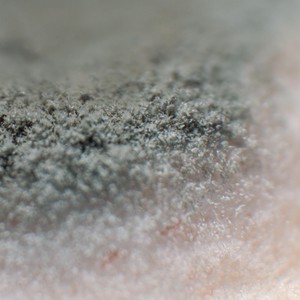
Irene

Neraev
热门歌曲
-
Neraev、Woman's Touch、Good Mood 4.21 MB 04:36
-
-
Neraev、Woman's Touch、Kub0 3.48 MB 03:47
-
Neraev、Woman's Touch 3.47 MB 03:47
-
Neraev 3.11 MB 03:23
-
Neraev、INARI-SOUND 2.59 MB 02:49
-
Neraev、Woman's Touch 3.47 MB 03:47
-
Neraev 3.22 MB 03:30
-
-
Blame Your Genes、Neraev 3.8 MB 04:08
-
Kub0、Neraev、Jakub Krajnak、Kristína Rypáková 3.25 MB 03:32
-
Neraev 3.71 MB 04:03
-
Blame Your Genes、Neraev 4.33 MB 04:43